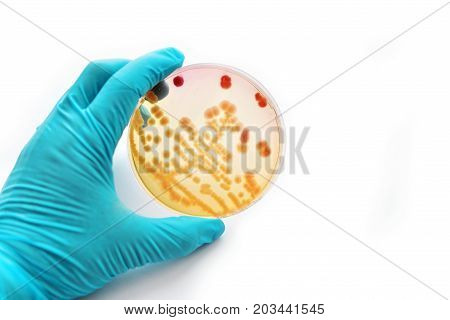
Colonies of bacteria in petri dish (MacConkey agar)

Сохранить с подпиской Bigstock. Подробнее >
закрыть
изображение
изображения
macconkey
стоковые фотографии
(Всего результатов: 179)